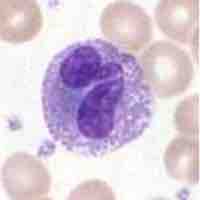
Thumbnail

Section 3
White Blood Cells
Book
Version 29
By Boundless
By Boundless
Boundless Anatomy and Physiology
Physiology
by Boundless
3 concepts
Types of WBCs
The different types of white blood cells (leukocytes) include neutrophils, basophils, eosinophils, lymphocytes, monocytes, and macrophages.

WBC Function
Each of the several types of white blood cells provide a specific major function in defending the body against infections.

WBC Formation
Haematopoiesis refers to the formation of blood cells components. It is necessary for vertebrate function.